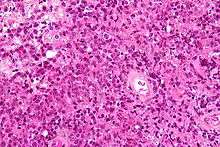

Primary central nervous system lymphoma
| Primary central nervous system lymphoma | |
|---|---|
![]() | |
| Brain magnetic resonance imaging showing primary central nervous system B-cell non-Hodgkin lymphoma of the sella turcica and hypothalamus, continuing to the tectum (intensely white areas in the middle). | |
| Classification and external resources | |
| Specialty | Hematology and oncology |
| ICD-9-CM | 200.5 |
| DiseasesDB | 29451 |
| eMedicine | article/1157638 |
A primary central nervous system lymphoma (PCNSL), also known as microglioma and primary brain lymphoma,[1] is a primary intracranial tumor appearing mostly in patients with severe immunosuppression (typically patients with AIDS). PCNSLs represent around 20% of all cases of lymphomas in HIV infections (other types are Burkitt's lymphomas and immunoblastic lymphomas). Primary CNS lymphoma is highly associated with Epstein-Barr virus (EBV) infection (> 90%) in immunodeficient patients (such as those with AIDS and those iatrogenically immunosuppressed),[2] and does not have a predilection for any particular age group. Mean CD4+ count at time of diagnosis is ~50/uL. In immunocompromised patients, prognosis is usually poor. In immunocompetent patients (that is, patients who do not have AIDS or some other immunodeficiency), there is rarely an association with EBV infection or other DNA viruses. In the immunocompetent population, PCNSLs typically appear in older patients in their 50's and 60's. Importantly, the incidence of PCNSL in the immunocompetent population has been reported to have increased more than 10-fold from 2.5 cases to 30 cases per 10 million population.[3][4] The cause for the increase in incidence of this disease in the immunocompetent population is unknown.
Classification
Most PCNSLs are diffuse large B cell non-Hodgkin lymphomas.[5][6]
Signs and symptoms
A primary CNS lymphoma usually presents with seizure, headache, cranial nerve findings, altered mental status, or other focal neurological deficits typical of a mass effect.[7][8] Systemic symptoms may include fever, night sweats, or weight loss.Other symptoms include
- diplopia
- dysphagia
- vertigo
- monocular vision loss
- progressive dementia or stupor in patients with a nonfocal neurologic exam and minimal abnormalities on MRI (more common in AIDS patients)
- facial hypoesthesia[9]
Diagnosis
The definitive diagnosis is arrived at from tissue, i.e. a biopsy, by a pathologist.
MRI or contrast enhanced CT classically shows multiple ring-enhancing lesions in the deep white matter. The major differential diagnosis (based on imaging) is cerebral toxoplasmosis, which is also prevalent in AIDS patients and also presents with a ring-enhanced lesion, although toxoplasmosis generally presents with more lesions and the contrast enhancement is typically more pronounced. Imaging techniques cannot distinguish the two conditions with certainty, and cannot exclude other diagnoses. Thus, patients undergo a brain biopsy.
Treatment
Surgical resection is usually ineffective because of the depth of the tumour. Treatment with irradiation and corticosteroids often only produces a partial response and tumour recurs in more than 90% of patients. Median survival is 10 to 18 months in immunocompetent patients, and less in those with AIDS. The addition of IV methotrexate and folinic acid (leucovorin) may extend survival to a median of 3.5 years. If radiation is added to methotrexate, median survival time may increase beyond 4 years. However, radiation is not recommended in conjunction with methotrexate because of an increased risk of leukoencephalopathy and dementia in patients older than 60.[10] In AIDS patients, perhaps the most important factor with respect to treatment is the use of highly active anti-retroviral therapy (HAART), which affects the CD4+ lymphocyte population and the level of immunosuppression.[11] The optimal treatment plan for patients with PCNSL has not been determined. Combination chemotherapy and radiotherapy at least doubles survival time, but causes dementia and leukoencephalopathy in at least 50% of patients who undergo it. The most studied chemotheraputic agent in PCNSL is methotrexate (a folate analogue that interferes with DNA repair). Methotrexate therapy in patients with PCNSL typically requires hospitalization for close monitoring and intravenous fluids. Leucovorin is often given for the duration of the therapy. Standard chemotherapeutic regimens for lymphoma such as CHOP are ineffective in PCNSL, probably due to poor penetration of the agents through the blood brain barrier.[11]
Newer treatments, such as high dose chemotherapy combined with stem cell transplant are proving to increase survival by years.
Prognosis
In immunocompetent patients
The initial response to radiotherapy is often excellent, and may result in a complete remission. However,the duration of response with radiotherapy alone remains short, with median survival after treatment with radiotherapy just 18 months. Methotrexate based chemotherapy markedly improves survival,with some studies showing median survival after methotrexate chemotherapy reaching 48 months.[12]
In AIDS patients
Patients with AIDS and PCNSL have a median survival of only 4 months with radiotherapy alone. Untreated, median survival is only 2.5 months, sometimes due to concurrent opportunistic infections rather than the lymphoma itself. Extended survival has been seen, however, in a subgroup of AIDS patients with CD4 counts of more than 200 and no concurrent opportunistic infections, who can tolerate aggressive therapy consisting of either methotrexate monotherapy or vincristine, procarbazine, or whole brain radiotherapy. These patients have a median survival of 10–18 months. Of course, highly active antiretroviral therapy (HAART) is critical for prolonged survival in any AIDS patient, so compliance with HAART may play a role in survival in patients with concurrent AIDS and PCNSL.[12]
References
- ↑ "CNS lymphoma, primary information". Diseases Database. Retrieved 17 April 2011.
- ↑ Fine HA, Mayer RJ (December 1993). "Primary central nervous system lymphoma". Ann. Intern. Med. 119 (11): 1093–104. doi:10.7326/0003-4819-119-11-199312010-00007. PMID 8239229.
- ↑ Eby NL, Grufferman S, Flannelly CM, Schold SC, Vogel FS, Burger PC (December 1988). "Increasing incidence of primary brain lymphoma in the US". Cancer. 62 (11): 2461–5. doi:10.1002/1097-0142(19881201)62:11<2461::aid-cncr2820621135>3.0.co;2-m. PMID 3179963.
- ↑ Corn BW, Marcus SM, Topham A, Hauck W, Curran WJ (June 1997). "Will primary central nervous system lymphoma be the most frequent brain tumor diagnosed in the year 2000?". Cancer. 79 (12): 2409–13. doi:10.1002/(sici)1097-0142(19970615)79:12<2409::aid-cncr17>3.3.co;2-2. PMID 9191531.
- ↑ Lukes RJ, Collins RD (October 1974). "Immunologic characterization of human malignant lymphomas". Cancer. 34 (4 Suppl): 1488–503. doi:10.1002/1097-0142(197410)34:8+<1488::aid-cncr2820340822>3.0.co;2-c. PMID 4608683.
- ↑ Jellinger K, Radaskiewicz TH, Slowik F (1975). "Primary malignant lymphomas of the central nervous system in man". Acta Neuropathol. Suppl 6 (Suppl 6): 95–102. doi:10.1007/978-3-662-08456-4_16. PMID 1098380.
- ↑ Bataille B, Delwail V, Menet E, et al. (February 2000). "Primary intracerebral malignant lymphoma: report of 248 cases". J. Neurosurg. 92 (2): 261–6. doi:10.3171/jns.2000.92.2.0261. PMID 10659013.
- ↑ Herrlinger U, Schabet M, Bitzer M, Petersen D, Krauseneck P (July 1999). "Primary central nervous system lymphoma: from clinical presentation to diagnosis" (PDF). J. Neurooncol. 43 (3): 219–26. PMID 10563426.
- ↑ Primary CNS Lymphoma at eMedicine
- ↑ Deangelis LM, Hormigo A (October 2004). "Treatment of primary central nervous system lymphoma". Semin. Oncol. 31 (5): 684–92. doi:10.1053/j.seminoncol.2004.07.011. PMID 15497122.
- 1 2 Primary CNS Lymphoma~treatment at eMedicine
- 1 2 Primary CNS Lymphoma~followup at eMedicine
External links
- MedPix Teaching File MR Scans of Primary Brain Lymphoma
